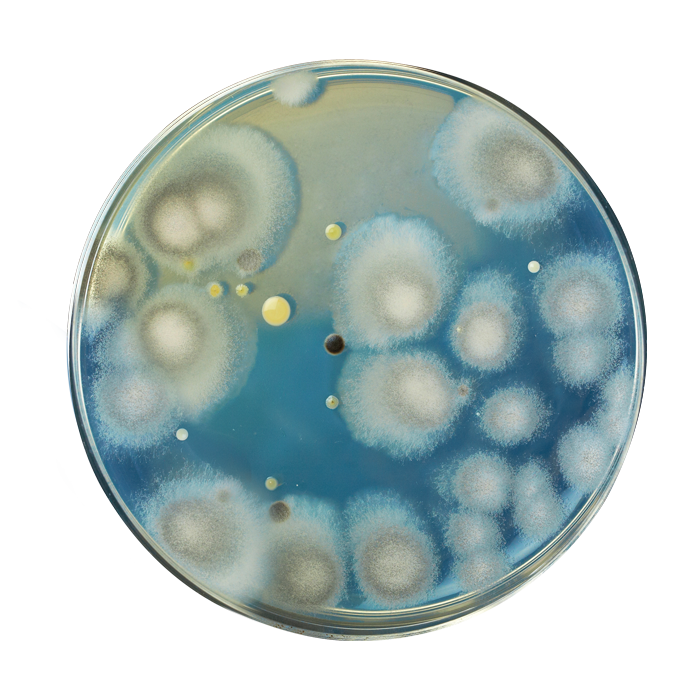

Safe hygiene and health for everyone!
A real help against the most common bacteria
Bacterial infections’ spread in hospitals is becoming a very huge and worrying problem. Many are the causes of the spreading of these infections and the most common one is the very low level of hygiene and sanitization in hospital facilities.
It’s well-known that cleaning equipment is the basic and fundamental instrument to clean and sanitize any environment; but right due to its main function “to clean and collect dirt”, this cleaning equipment may also be a vehicle of bacteria spreading and proliferation.
Consequently, it’s very important to choose the right cleaning equipment to try to highly reduce bacterial infections.
Considering all these issues Filmop has developped its “A-B PLUS” cleaning system: this specific cleaning equipment has been treated with anti-bacterial additives to slow down the growth of microorganism, bacteria and fungi.
A sanitization cleaning system for hospitals…and not only
- Hospitals (both low-risk common areas and high-risk areas - such as operating theatres, infection disease wards, intensive care wards, etc..)
- Nursing homes
- Public facilities such as schools, nursery schools, food industries, banks, airports, railway stations, etc.)
Health for everyone
- For patients and people
- For cleaning operators
- For environment
Filmop, always engaged in a policy of sustainable development, is convinced that a healthy world is really important for man’s and animals’ good health and wellness and, consequently, it uses additives that are not dangerous and regularly tested to assure their efficacy and safety.
These additives are added to the product during its production and cannot melt away in water or move outside; so they are not dangerous either for man or for water environment.
ANTIBACTERIAL PLASTICS
The materials with which the plastic components of the system are made, treated with zinc pyrithione or silver ions, have been subjected to efficacy tests by an independent external laboratory that demonstrated a reduction of 99.9% for Escherichia coli and Staphylococcus Aureus contamination.
The anti-bacterial action of the plastic materials is guaranteed for the whole life cycle of the product.
![]() |
![]() |
|
|
BACTERIA ON REGULAR POLYMER SURFACE |
BACTERIA ON A-B PLUS POLYMER SURFACE |
ANTI-BACTERIAL MICROFIBER
The microfiber used for the mops and cloths, treated with silver ions, was tested for effectiveness and confirmed a great antibacterial activity against the bacteria Staphyloccocus Aureus and Klebsiella Pneumoniaea.
The microfiber anti-bacterial action is guaranteed for the whole life cycle of the product.
Alpha A-B PLUS made of anti-bacterial recyclable material
Cleaning equipment, especially trolleys, are the main instruments to support operator in carrying out the sanitization service; but right due to their function they can become a vehicle of bacteria’s transmission and spreading: therefore, meticulously sanitize equipment on a daily basis becomes crucial.
Filmop manual cleaning equipment and trolleys have always been made of high intensity polypropylene, making all components easy to clean, from wheels to handles, through doors, walls and drawers. Besides, they are characterized by non-porous surfaces that do not absorb dirt.
In addition to these important advantages, Filmop ensures the maximum in terms of hygiene with A-B Plus: the trolley is treated with anti-bacterial additives to further protect it against the proliferation of bacteria, fungi and molds.
- Closed section to meet higher hygiene and safety standards
- Smooth, rounded surfaces for easy cleaning
- Full upright separate compartments (wet mopping - storing - waste collection) for high hygiene
- Wide opening drawers for easy access
- Soft, silent cover closing of the bag holder
- Non-marking silent rubber wheels
With Top-Down pre-soaking system for optimal results in terms of:
- Ecology: less waste of chemicals and water compared to traditional systems
- Reduction of bacterial cross-contamination: 1 mop per room
- Reduced time and costs for cleaning
With Equodose on-demand soaking system to ensure the maximum in terms of:
- Saving of cleaning solution: only the necessary mops are soaked
- Flexibility: possibility to adjust the dosage for each individual mop
- High hygiene standard: allows you to clean each room with a different mop
Both soaking systems are compatible with:
Uniko foldable mop holder in antibacterial plastic
- Automatic mop fixing system to eliminate bending
- Release system designed to avoid contact with the dirty mop
- Lock System fitting for optimum cleaning of walls and ceilings
Mop holder made of aluminum and antibacterial plastic
- Trapezoidal shape to easily clean even hard-to-reach areas
- Flat and linear edges to ensure excellent adherence to the floor
- Lock System fitting for easy cleaning of vertical surfaces
The A-B Plus ultra-microfiber mop for dusting, washing, and disinfecting indoor floors
and the Multi-T A-B Plus microfiber cloth for wet or dry cleaning of any surface complete the system.
Antibacterial cloths allow proper risk control thanks to color coding.
![]() |
![]() |
|
Alpha A-B Plus facilitates the cleaning and disinfection procedures respecting the environment
GREEN PRODUCT
Partially made with plastic components certified "Plastic Second Life"
100% RECYCLABLE
The absence of screws and metal components make it totally recyclable
The value of CAM compliance
The A-B Plus system complies with Italian legislation on minimum environmental criteria
✓ Trolleys equipped with buckets in different colors, made of recycled plastic
✓ Flat, reusable microfibers with dTex ≤ 1 for surface and floor cleaning